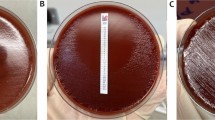

Abstract
Tetracycline has been used with other antibiotics in treatment of Helicobacter pylori infection. However, tetracycline resistance has developed in H. pylori clinical isolates, rendering treatment failure. Mutations in 16S rRNA genes have been reported to mediate tetracycline resistance in some isolates. The diversity of tetracycline resistance cases suggests multiple genes are involved. HP1165, a putative tetracycline resistance gene in H. pylori 26695, displays 49.8% identity to the tetracycline efflux gene tetA (P) from Clostridium perfringens. To determine the function of the HP1165 gene in H. pylori, the tetracycline resistance phenotype was investigated, transcription of HP1165 was examined by RT-PCR, and a ΔHP1165 mutant was generated by insertion of the pBCα3 plasmid. The results showed that strains harboring HP1165 were induced to intermediate level resistance in the laboratory (minimum inhibitory concentration=4–6 μg/ml). No mutation was found at or near the tetracycline binding sites of the 16S rRNA gene. The gene was transcribed both in the induced tetracycline resistant and wild type strains, indicating translational or posttranslational control of gene function. Mutation of HP1165 gene resulted in increased tetracycline susceptibility and loss of inducible tetracycline resistance, suggesting that the HP1165 gene is involved in the inducible tetracycline resistance in H. pylori.
Similar content being viewed by others
Avoid common mistakes on your manuscript.
Introduction
Helicobacter pylori, the microaerophilic, Gram-negative bacterium occurring in over 50% of the world population, causes chronic gastritis, peptic ulcer, and is often associated with gastric carcinoma and B-cell mucosa associated lymphoid tissue lymphoma (Feldman 1998). To treat H. pylori infection, tetracycline has been used in combination with other antibiotics and is very effective in most cases (Graham and Qureshi 2000; Osato et al. 2001; Perri et al. 2001; Sicilia et al. 2000). However, tetracycline resistance at different levels has emerged in patient isolates from Korea, Japan, Australia, The Netherlands, Brazil, and other countries (Kwon et al. 2000; Dailidiene et al. 2002; Gerrits et al. 2002; Ribeiro et al. 2004; Trieber and Taylor 2002). Development of tetracycline resistance has decreased the efficacy of therapies, with the potential for rendering treatment failure.
Trieber and Taylor (2002) reported that the triple-base-pair substitution AGA (965–967)→TTC mediated high-level tetracycline resistance in two H. pylori patient isolates from Australia. Since then, several references were reported similar or identical discovery, suggesting that mutations in 16S rRNA gene is a relatively common mechanism of tetracycline resistance in H. pylori (Dailidiene et al. 2002; Gerrits et al. 2002; Ribeiro et al. 2004; Trieber and Taylor 2002). The mutations are located in the loop of helix 31, the primary binding site of tetracycline. Mutations in this primary binding site appear to affect the affinity of the drug-ribosome interaction and reduce the efficacy of tetracycline as a translational inhibitor. However, there are tetracycline resistant isolates that do not have mutations in 16S rRNA gene (Dailidiene et al. 2002). Berg et al. (2002) suggested that “mutations in 16S rRNA gene cover much but not all of the clinical tetracycline resistance cases”. The diversity of tetracycline resistance phenotypes in clinical isolates, particularly in levels of resistance, stability, and inducibility suggests that multiple genes or mechanisms may be involved in tetracycline resistance of H. pylori.
In addition to mutations on 16S rRNA, three other mechanisms may be involved in tetracycline resistance in bacteria. These include energy-dependent efflux of tetracycline, ribosomal protection, and enzymatic inactivation of tetracycline (Roberts 1996; and Chopra and Roberts 2001). The efflux mechanism is common both in Gram-negative and Gram-positive bacteria. It is carried out by energy-dependent membrane-associated proteins which pump tetracycline out of the cell at a rate equal to or greater than its uptake. This keeps the intracellular tetracycline level low enough to allow protein synthesis. In Gram-negative bacteria, the efflux tetracycline resistance determinant is usually composed of two elements, tetA gene, which encodes an efflux protein, and tetR gene, which encodes a repressor protein. In the absence of tetracycline, the TetR repressor binds to the gene operators, and blocks tetA/R gene transcription. In the presence of tetracycline, the transcription of the genes is induced by decreasing the affinity of the TetR repressor for two operator sites (Luo and Farrand 1999). Recent studies by Wu et al. (2005) reported that disruption of HP1165 gene in patient strains showing stable, high-level resistance (MIC=30 μg/ml) had no effect on the phenotype. They did not however examine intermediate-level tetracycline resistance. Their work also showed no changes to the 16S tetracycline binding sites in this strain. Their results indicate a possible third mechanism of tetracycline resistance in H. pylori.
Publication of the complete genome sequence of H. pylori 26695 revealed a putative tetracycline resistance gene, HP1165, which shares 49.8% identity with the well studied tetracycline efflux gene tetA (P) in Clostridium perfringens (Kennan et al. 1997). The putative 386-amino-acid transmembrane efflux protein encoded by HP1165 is homologous to the 420-amino-acid transmembrane efflux protein TetA(P) from C. perfringens. TetA(P), an inducible 46-kD protein containing 12 transmembrane segments, is responsible for the active efflux of tetracycline from C. perfringens (Bannam and Rood 1999). Further database search showed that HP1165 in H. pylori 26695 displays 98% identity to the JHP1092 gene in H. pylori J99 and 40-44% homology to the multidrug transporters in Campylobacter jejuni and Borrelia burgdorferi. Interestingly, previous work in our lab showed that the putative tetracycline resistance gene (HP1165) is prevalent in Helicobacter laboratory strains and clinical isolates (Rakshit 2000). However, the actual role of HP1165 in expression and involvement in tetracycline resistance of H. pylori remains unknown.
In this study, we performed tetracycline susceptibility tests in H. pylori strains harboring the HP1165 gene. We also examined the transcription of the gene in H. pylori 26695 and tetracycline resistant isolates derived from H. pylori 26695. A ΔHP1165 mutant of H. pylori was generated by molecular cloning and insertional disruption of the gene to assess involvement of the gene in tetracycline resistance.
Materials and methods
Bacterial strains, plasmid and culture conditions
Three HP1165 positive strains (H. pylori ATCC 26695, patient strains 1 and 2) and one HP1165 negative strain (H. mustelae ATCC 43772) were tested for tetracycline resistance. H. pylori ATCC 26695 was used in the extensive study of HP1165 gene function. H. pylori ATCC 26695 and H. mustelae ATCC 43772 were purchased from American Type Culture Collection (ATCC, Rockville, MD). Two strains, kindly provided by Dr David Graham at Baylor College of Medicine, were from patients previously treated with tetracycline. H. pylori strains were routinely grown on Brucella agar plates supplemented with 10% sheep blood and 10 mg/l nalidixic acid. Tetracycline was supplemented to maintain tetracycline resistant isolates. Transformants of H. pylori 26695 were selected on plates containing kanamycin 10 μg/ml. The broth culture for gene transcription analysis contains 7.5 ml Brucella broth (BBL, Timonium, MD), 2.5 ml fetal bovine serum, 0.02% glucose, and nalidixic acid 10 ug/ml. The cultures were incubated at 37°C under microaerobic conditions (5–7% O2, 10% CO2) in anaerobic jars.
E. coli ER 1793 (New England BioLabs, Beverly, MA) was used for cloning of HP1165 and generation of ΔHP1165 mutants. It was grown in Luria-Bertani medium (LB medium, BBL, Timonium, MD). Ampicillin or kanamycin (50 μg/ml) was added for selection when necessary. The shuttle vector pBCα3 was a kind gift from J.J.E. Bijlsma (Vrijie Universiteit Amsterdam, The Netherlands).
Tetracycline susceptibility test
The susceptibility of Helicobacter to tetracycline was evaluated by minimal inhibitory concentration (MIC). The MIC was routinely determined with the Epsilometer test (E test) (Glupczynski et al. 1991). Each Brucella blood agar plate was inoculated with approximately 2×108 cells prepared from a fresh H. pylori culture and E test strips (E test, Remel, Inc.) were applied to the agar surface. The plates were incubated for 3 days at 37°C under microaerobic conditions. MIC was determined by reading the intercept of the zone of inhibition with the graduated E test strip. The isolates were considered resistant when the MIC for tetracycline was above 2 μg/ml (Kwon et al. 2000).
Induction of tetracycline resistance
Induction of tetracycline resistance was performed by selecting resistant colonies that arose in the inhibitory zone of a disk containing 8 μg tetracycline. Sterile discs loaded with 8 μg of tetracycline were applied to plates inoculated with the bacterium. After 5 days of prolonged incubation, resistant colonies that grew within the zone of inhibition were collected and transferred to fresh plates containing tetracycline (2 μg/ml). The resistant isolates were maintained on tetracycline-containing plates. The MICs of the induced resistant isolates were measured after three stable passages.
Sequencing of 16S rRNA gene
The 16S rRNA gene was PCR amplified from the genomic DNA of the induced tetracycline resistant strain and the laboratory maintained ATCC 26695 strain, respectively. Oligonucleotide primers (Integrated DNA Technologies, Inc.) used for PCR were based on the genome sequence of H. pylori 26695. The forward primer was 5′-TTTATGGAGAGTTTGATCC-3′ and the reverse primer was 5′-AGGAGGTGATCCAACCGCA-3′ (Gerrits et al. 2002). Expected size of the product was 1,494 bp. The PCR products were purified from agarose gels using Zymoclean TM Gel DNA Recovery kit (ZYMO Research, Orange, CA). Sequencing of the gene was performed by Northwoods DNA, Inc. (Bemidji, MN). DNA sequence analysis and blast analysis were performed using the tools in Biology Workbench at San Diego Supercomputer Center (http://www.workbench.sdsc.edu).
Detection of HP1165 expression in H. pylori 26695
mRNA of HP1165 was detected by RT-PCR. Total RNAs were isolated from H. pylori 26695 and laboratory induced tetracycline resistant isolates using SV (spin or vacuum) Total RNA Isolation Kit from Promega (Madison, WI) with slight modification. The concentration of RNA was determined by measuring absorbance at 260 nm using a Beckman DU 640B spectrophotometer. RT-PCR was performed using HP1165 mRNA specific primers and Access One-Step RT-PCR System (Promega, Madison, WI). The expected product size was 624 bp. The reactions were held at 48°C for 45 min, 94°C for 2 min, followed by 40 cycles of PCR with parameters of 94°C for 30 s, 56°C for 1 min, 68°C for 2 min. The primers used for reverse transcription and PCR of HP1165 were 5′-AGGGAGTTCTTTGGGATCGT-3′ (forward, position 435–454 of the HP1165 ORF), and 5′-TCCAGACTGCTGAGCGATAA-3′ (reverse, position 1,039 to position 1,058 of the HP1165 ORF). The primers for the reverse transcription and PCR of ureA were 5′-CGGCTCACACTTCCATTTCT-3′ (forward, position 423–442 of the urea ORF), and 5′-CATCGCTTTTAGCGCCAT-3′ (reverse, position 674–688 of the ureA ORF). The products were visualized by electrophoresis on 1.5% TAE (Tris Acetate EDTA) agarose gel because the product of the internal control, ureA, was only 265 bp.
DNA manipulation
All standard methods of DNA manipulation were performed according to the protocols of Sambrook et al. (1989). Restriction endonuclease, ligase and Taq DNA polymerase were obtained from Promega and were used according to manufacturer’s instructions. Plasmids were routinely isolated from E. coli strains using either the Wizard Plasmid Miniprep Kit (Promega, Madison, WI) or the alkaline lysis method. Genomic DNA from H. pylori was isolated using Wizard Genomic DNA Purification Kit (Promega, Madison, WI). E. coli cells were transformed by electroporation (Woodall 2003). H. pylori were transformed by natural transformation (Wang et al. 1993).
Molecular cloning
A 666 bp fragment (tet666), defective at the 5′- and 3′-ends of the coding region, was amplified by PCR from the chromosomal DNA of H. pylori ATCC 26695. The forward primer with XbaI site was 5′-TCTGTCTAGAAACAACACAAGCGAACTC-3′. The reverse primer with BamHI site was 5′-TGTAGGATCCTTTAGCGGATTTGATGAG CC-3′. The vector used was pBCα3, carrying a kanamycin resistance cassette that is functional in both E. coli and H. pylori (Bijlsma et al. 1999). The pBCα3 plasmid self-replicates in E. coli but is a suicide vector for H. pylori. The ligation product was transformed into E. coli ER 1793. Identification of the recombinant plasmid (tet666-pBCα3) was made by restriction enzyme analysis and sequencing.
Construction of HP1165 mutant strain of H. pylori ATCC 26695
Helicobacter pylori 26695 was naturally transformed with the tet666-pBCα3 recombinant plasmid. The integration of the whole plasmid into the chromosomal DNA by a single homologous crossover lead to the deletion of the 5′ and 3′ ends of the coding region; the chromosomal DNA of the mutant carries duplicates of incomplete HP1165 genes, defective at the 5′- and 3′-end of the coding region. Selection of the mutant was accomplished using kanamycin-containing (10 μg/ml) medium because the cells were unstable and could not be isolated on higher concentrations initially. The cells were later transferred to higher concentrations of kanamycin (30 mg/ml).
Plasmid rescue was used to obtain molecular evidence of integration of the recombinant plasmid and disruption of HP1165 gene in the genome of H. pylori (Frank et al. 2003). Chromosomal DNA of the mutant was isolated and restricted with BamHI or EcoRI. Chromosomal fragments were ligated and transformed into E. coli ER1793 with selection on kanamycin. Plasmids were isolated from single colonies grown on the selective medium and sequenced using the aphA3-L primer (5′-TCTTACCTATCACTCAAATGG-3′).
Transformation of H. pylori
Natural transformation of H. pylori was performed on the agar surface, as described by Wang et al. with modifications (Wang et al. 1993). Briefly, fresh recipient cells (48 h growth on Brucella agar plate) were harvested from the plate and transferred as thick patches (8–10 mm in diameter) onto a fresh plate. Aliquots of DNA, 0.3–2 μg in 10 μl TE (Tris–HCl EDTA) buffer, were spotted directly onto the inoculated patches. After 18 h of incubation, the bacteria were collected using a swab and transferred onto plates containing kanamycin (10 μg/ml) to select for transformants.
Results
Tetracycline resistance of Helicobacter
To investigate the correlation between the HP1165 positive genotype and tetracycline resistance phenotype, the tetracycline susceptibility test and tetracycline resistance induction were performed in four Helicobacter strains (Fig. 1). H. pylori 26695, patient strain 1, and patient strain 2, all of which harbor the HP1165 gene in the genome, were all susceptible to tetracycline in vitro, with MICs of less than 0.9 μg/ml. When the three strains were exposed to 8 μg of tetracycline loaded onto a blank filter paper disc, a zone of inhibition appeared after 2–3 days of incubation. However, when the plates were incubated an additional 24–48 h, resistant colonies were isolated from within the zone of inhibition surrounding the disc and were able to grow on tetracycline-containing plates (2 μg/ml). After three stable passages on the tetracycline plates, the MICs were determined to be between 4 and 6 μg/ml, which was termed intermediate resistance. However, removal of tetracycline from the plates for even one passage made the MICs of the resistant isolates drop dramatically. This indicated that the observed tetracycline resistance was transient and inducible.
Interestingly, the HP1165 negative strain H. mustelae ATCC 43772 showed high resistance to tetracycline (MIC=24–28 μg/ml) with or without prior exposure to tetracycline. This suggested that the high-level tetracycline resistance in H. mustelae was constitutive and the mechanism of resistance was different from that of H. pylori inducible resistant isolates.
Sequencing of 16S rRNA gene
Since mutations in 16S rRNA gene were found to mediate tetracycline resistance in a few patient isolates, the 16S rRNA genes from the laboratory-induced resistant strain and the laboratory-maintained susceptible strain of H. pylori 26695 were sequenced and compared with the 16S rRNA gene sequence in the GenBank (Tomb et al. 1997). The analysis showed that neither the induced tetracycline resistant strain nor the lab-maintained susceptible H. pylori 26695 had sequence identical to the published 16S rRNA gene of H. pylori 26695 (data not shown). For the induced tetracycline resistant strain, the 16S rRNA gene had most of the same mutations of the lab maintained H. pylori 26695, which was in accordance with the fact that the former was derived from the latter. In addition, it had three unique mutations, C addition between C17 and T18, C493G, and G addition between G530 and T531 (E. coli 16S rRNA numbering). However, none of the mutations were within or near the putative tetracycline binding sites, indicating that it was not likely that the induced tetracycline resistance resulted from a 16S rRNA gene mutation. Previous studies by Trieber and Taylor (2002) revealed a triple mutation AGA (965–967)→TTC at the primary tetracycline binding site, mediating tetracycline resistance in patient isolates. In this study, no mutation was found at AGA965–967.
Transcription of HP1165 in H. pylori
Homology analysis of the putative tetracycline resistance gene HP1165 indicates that HP1165 gene may be, at least in part, responsible for the induced tetracycline resistance. To detect transcription of the gene, mRNAs of HP1165 from the laboratory-induced tetracycline resistant strain and the tetracycline susceptible ATCC 26695 were examined by reverse transcription (RT) PCR. H. pylori 26695 cells cultured for 40 h on Brucella blood agar plates without tetracycline and the laboratory-induced tetracycline resistant H. pylori cells grown 40 h on plates containing tetracycline (2 μg/ml) were used for RNA isolation and RT-PCR. Presence of the RT-PCR product of 624 bp indicated mRNA transcription of the HP1165 gene. As shown in Fig. 2, mRNA of HP1165 gene was not only found in the lab-induced tetracycline resistant strain (MIC=4–6 μg/ml) in the presence of tetracycline but also in the tetracycline susceptible H. pylori 26695 strain (MIC=0.5 μg/ml) in the absence of tetracycline. Presence of mRNA in the tetracycline susceptible H. pylori 26695 strain in the absence of tetracycline was not expected. According to previous literature (Luo and Farrand 1999), expression of the efflux proteins in Gram-negative bacteria are usually controlled by a repressor. In the absence of tetracycline, the repressor binds to the gene operators and blocks the efflux gene transcription.
RT-PCR analysis of tetracycline resistant and susceptible H. pylori strains. Lane 1, positive control from RT-PCR Kit (Promega, Madison, WI); lane 2, H. pylori 26695; lane 3, no reverse transcriptase, H. pylori ATCC 26695; lane 4, tetracycline resistant strain; lane 5, no reverse transcriptase, resistant strain; lane 6, genomic DNA positive control
Investigation of the transcription status of HP1165 in the tetracycline susceptible H. pylori 26695 strain led to examination of mRNA at various growth phases of the cells. Cells grown in liquid culture were detected for the presence of mRNA at lag phase (6 h), exponential phase (24 and 40 h), and stationary phase (72 h) of growth. The results showed that mRNA was present in any of the three growth phases (Fig. 3). Therefore, transcription of the HP1165 gene in the tetracycline susceptible H. pylori 26695 strain was constitutive. However, when the intensity of the band on the gel was considered, there may be differences in the quantity of mRNA among the three growth phases. Nevertheless, little information can be gleaned from these experiments since the RT-PCR was not quantitative.
RT-PCR analysis of three growth phases of H. pylori ATCC 26695. H. pylori 26695 cells grown in liquid culture were examined for the presence of mRNA at lag phase (6 h, lane 1), log phase (24 h, lane 3, and 40 h, lane 5), and stationary phase (72 h, lane 7). Lane 2, no reverse transcriptase; lane 4, 24 h culture, no reverse transcriptase; lane 6, 40 h culture, no reverse transcriptase; lane 8, 72 h culture, no reverse transcriptase
Generation and characterization of a ΔHP1165 mutant of H. pylori
Assessment of involvement of the putative tetracycline resistance gene in development of the intermediate tetracycline resistance in the laboratory-induced resistant strain was performed by construction of a HP1165 gene knock-out mutant of H. pylori 26695 and characterization of phenotypic changes. Successful cloning of tet666 into pBCα3 was confirmed by a series of restriction enzyme analyses and sequencing. The recombinant plasmid tet666-pBCα3 was used to transform H. pylori ATCC 26695. A single homologous crossover led to integration of the plasmid and disruption of HP1165 gene. Mutants were selected on kanamycin-containing plates (10 μg/ml). A few tiny colonies were seen on kanamycin selective plates at 7 days after transformation. PCR amplifications from the genome showed the absence of the complete HP1165 ORF and presence of the kanamycin cassette (from the pBCα3) in the mutant (data not shown). Integration of the plasmid into the ORF of HP1165 gene was confirmed by plasmid rescue and sequencing.
RT-PCR of the HP1165 mutant strain was performed with the primers described above, using ureA as an internal control (data not shown). After DNase treatment, the reactions resulted in no PCR product of 624 bp, confirming the presence of the insert into HP1165.
The results of tetracycline susceptibility tests showed that mutation of HP1165 gene resulted in hypersensitivity to tetracycline (data not shown). The MIC (Mean=0.05 μg/ml) decreased ten fold in comparison with that of wild type (MIC=0.5 μg/ml). When induction of tetracycline resistance was performed, the ΔHP1165 mutant failed to give rise to any tetracycline resistant colonies when exposed to an 8 μg tetracycline disc. No bacterial growth was found on tetracycline-containing BAP plates (2 μg/ml). This experiment was repeated five times. In contrast, the wild type was able to be induced to intermediate resistance (MIC=4–6 μg/ml) in each of the five trials and isolated colonies grew well on BAP plates containing 2 μg/ml of tetracycline. Gram staining showed that the mutant cells stained Gram-negative, however, the cell morphology had changed dramatically. Each cell contained 2–3 large inclusion bodies which stained less intensely than other parts of the cytoplasm. Wild type cells did not show changes in the cell morphology, indicating that an unknown substance may have accumulated in the cytoplasm in the mutant.
The mutant grew normally on Brucella blood agar plates and produced viable frozen stock cultures. However, the mutant showed slightly slower growth rate; 4–5 days were required to grow to a full plate, compared with 3 days for wild type. The mutant was urease and oxidase positive, as expected.
Discussion
The protein structure encoded by HP1165, including the location of transmembrane segments and intervening loops, was predicted using TMHMM 2.0 of Biology Workbench, to determine whether it has a structure typical of efflux proteins, as shown previously by Bannam and Rood (1999). The putative protein encoded by HP1165 is composed of 386 amino acids. It is characterized by 12 segments of hydrophobic amino acids which possibly form α-helices. As expected, the protein contains 12 transmembrane segments, with both N-terminus and C-terminus located in the cytoplasm. The first six membrane-spanning segments and the last six segments were intervened by a relatively long loop (33 amino acids) which is in the cytoplasm. This structure is similar to the TetA (P) efflux protein in C. perfringens, which also contains 12 transmembrane domains. The TetA (P) protein has been well studied and was found to be an active efflux pump of tetracycline (Bannam et al. 2004).
Helicobacter pylori 26695 and the two patient strains harboring the putative tetracycline resistance gene HP1165 were initially susceptible to tetracycline (MIC<0.9 μg/ml). However, with prolonged exposure to the diffusion of 8 μg of tetracycline from the disk, all three strains were induced to intermediate tetracycline resistance (MIC=4–6 μg/ml). Nevertheless, the inducible resistance was unstable; one passage of the laboratory-induced resistant strains without addition of tetracycline to the medium rendered the strain sensitive to tetracycline. It has been reported that a triple mutation from AGA to TTC at positions 965–967 of the 16S rRNA gene, the primary tetracycline binding site, mediated tetracycline resistance in some H. pylori patient strains (Trieber and Taylor 2002; Gerrits et al. 2002). In this study, sequencing of the 16S rRNA gene from the laboratory-induced tetracycline resistant strain showed no mutation at or near any of the tetracycline binding sites. These results were similar to that of Dailidiene et al. in which none of their ten metronidazole-induced tetracycline resistant mutants contained changes in the primary tetracycline binding sites in the 16S rRNA gene (Dailidiene et al. 2002) implying that some tetracycline resistant mutants had arisen as a function of non-rDNA genes. The laboratory-induced tetracycline resistant strain had no mutations in the 16S rRNA gene that are known to contribute to tetracycline binding, suggesting that other genes may be involved in the development of intermediate tetracycline resistance in H. pylori.
Disruption of the HP1165 gene in H. pylori 26695 by the 5′- and 3′- end deletion using tet666-pBCα3 clone resulted in hypersensitivity of the strain to tetracycline and loss of the inducible intermediate tetracycline resistance. The insertion mutation should not have any polar effect because HP1165 and its neighboring genes, HP1164 and HP1166, are not transcribed from a single operon. The open reading frame of HP1164, which encodes the thioredoxin reductase, and HP1166, which encodes glucose-6-phosphate isomerase, are on the positive DNA strand and in opposite orientation, while HP1165 is on the negative strand. Therefore, the phenotypic changes were caused by disruption of the target gene rather than a polar effect on down stream genes. The results indicated that HP1165 was necessary for the inducible tetracycline resistance in the laboratory-induced tetracycline resistant strain. In addition, loss of inducible tetracycline resistance in the mutant further confirmed that the tetracycline resistance of the laboratory-induced tetracycline resistant strain was not due to mutations in 16S rRNA gene.
RT-PCR analysis of the HP1165 gene showed that the gene was transcribed, not only in the laboratory-induced tetracycline resistant strain in the presence of tetracycline, but also in the tetracycline susceptible H. pylori 26695 in the absence of tetracycline. Transcription in the tetracycline susceptible strain H. pylori 26695 was constitutive as shown by expression of the protein during the various growth phases. It was concluded that other factors, possibly post-translational modification, must be responsible for variations in tetracycline resistance phenotypes.
Constitutive transcription of the HP1165 gene in H. pylori 26695 in the absence of tetracycline was not expected because transcription of efflux genes is usually repressed by a TetR repressor protein and induced by addition of tetracycline (Luo and Farrand 1999). For example, expression of TetA (P) protein in Clostridium is inducible in conjugative isolates. In non-conjugative strains, TetA (P) is constitutively expressed, giving rise to constitutive resistance (Saksena et al. 1993). Sequence searching for a tetR gene from the genome of H. pylori 26695 showed that there was no genes homologous to tetR gene, indicating that the repressor of the putative tetA (HP1165) was absent, which may explain constitutive transcription of the gene in H. pylori 26695 in the absence of tetracycline. However, that can not explain the susceptibility of the bacteria to tetracycline. In Gram-positive bacteria, tet (K) and tet (L) also had no repressor genes for regulation, but they may be regulated by translational attenuation (Schwarz et al. 1992). Therefore, expression of the HP1165 protein may be regulated by degradation of mRNA or attenuation of translation at the translation level. It is also possible that the protein function is regulated at the post-translation level by protein modifications, although no literature has reported functional regulation of efflux genes in bacteria. Post-translational modification seems quite feasible given the transient nature of the phenotype and yet constitutive nature of the genotype.
We found that the tetracycline resistant isolates induced in the laboratory reverted to tetracycline sensitivity after one passage without tetracycline in the media. This may serve as a reference to the antibiotic tests in clinics. When patient strains are cultured, the initial media does not contain tetracycline. As a result, the resistance is lost. Therefore, tetracycline resistance could play a role in treatment failure, yet the phenotype would be “hidden” during routine antimicrobial susceptibility testing. This partially answers the puzzle that H. pylori is quite sensitive to many antibiotics in the clinical tests but very difficult to treat in patients.
The work in this study suggested the involvement of the putative tetracycline resistance gene HP1165 in development of tetracycline resistance in H. pylori. It is now clear that multiple genes are involved in addition to the 16S rDNA. This contributes to a better understanding of the mechanisms of tetracycline resistance in H. pylori clinical isolates. Knowledge of mechanisms of tetracycline resistance in H. pylori, in this and other studies like this, may help clinics or drug designers to circumvent resistance problems and successfully eradicate the bacterium from patients.
Much work has yet to be done to further clarify the role of HP1165 gene. This includes recovering the phenotype by plasmid complementation in the mutant, expressing the protein in E. coli, characterizing the involvement of HP1165 gene in tetracycline resistance by using artificial membrane vesicles integrated with the purified protein and quantitative RT-PCR of HP1165 through the various stages of growth. Moreover, it is possible that HP1165 gene plays other roles in H. pylori. It will be very interesting to understand all of the functions of HP1165.
References
Bannam TL, Rood JI (1999) Identification of structural and functional domains of the tetracycline efflux protein TetA(P) from Clostridium perfringens. Microbiology 145(Pt 10):2947–2955
Bannam TL, Johanesen PA, Salvado CL, Pidot SJ, Farrow KA, Rood JI (2004) The Clostridium perfringens TetA(P) efflux protein contains a functional variant of the Motif A region found in major facilitator superfamily transport proteins. Microbiology 150(Pt 1):127–134
Bijlsma JJ, Vandenbroucke-Grauls CM, Phadnis SH, Kusters JG (1999) Identification of virulence genes of Helicobacter pylori by random insertion mutagenesis. Infect Immun 67:2433–2440
Bina JE, Alm RA, Uria-Nickelsen M, Thomas SR, Trust TJ, Hancock RE (2000) Helicobacter pylori uptake and efflux: basis for intrinsic susceptibility to antibiotics in vitro. Antimicrob Agents Chemother 44:248–254
Chopra I, Roberts M (2001) Tetracycline antibiotics: mode of action, application, molecular biology, and epidemiology of bacterial resistance. Microbiol Mol Biol Rev 65:232–260
Dailidiene D, Bertoli MT, Miciuleviciene J, Mukhopadhyay AK, Dailide G, Pascasio MA, Kupcinskas L, Berg DE (2002) Emergence of tetracycline resistance in Helicobacter pylori: multiple mutational changes in 16S ribosomal DNA and other genetic loci. Antimicrob Agents Chemother 46:3940–3946
Frank AC, Meyers KA, Welsh IC, O’Brien TP (2003) Development of an enhanced GFP-based dual-color reporter to facilitate genetic screens for the recovery of mutations in mice. Proc Natl Acad Sci USA 100(24):14103–14108
Feldman RA (1998) Migration, lifestyle and socio-economic factors. Neth J Med 52:241–245
Gerrits MM, de Zoete MR, Arents NL, Kuipers EJ, Kusters JG (2002) 16S rRNA mutation-mediated tetracycline resistance in Helicobacter pylori. Antimicrob Agents Chemother 46:2996–3000
Gerrits MM, Berning M, Van Vliet AH, Kuipers EJ, Kusters JG (2003) Effects of 16S rRNA gene mutations on tetracycline resistance in Helicobacter pylori. Antimicrob Agents Chemother 47:2984–2986
Glupczynski Y, Labbe W, Hansen F, Crokaert F, Yourassowsky E (1991) Evaluation of the E-test for quantitative antimicrobial susceptibility testing of Helicobacter pylori. J Clin Microbiol 29:2072–2075
Graham DY, Qureshi WA (2000) Antibiotic-resistant H.pylori infection and its treatment. Curr Pharm Des 6:1537–1544
Kennan RM, McMurry LM, Levy SB, Rood JI (1997) Glutamate residues located within putative transmembrane helices are essential for TetA(P)-mediated tetracycline efflux. J Bacteriol 179:7011–7015
Kwon DH, Kim JJ, Lee M, Yamaoka Y (2000) Isolation and characterization of tetracycline-resistant clinical isolates of Helicobacter pylori. Antimicrob Agents Chemother 44:3202–3205
Luo ZQ, Farrand SK (1999) Cloning and characterization of a tetracyline resistance determinant present in Agrobacterium tumefaciens C58. J Bacteriol 181:618–626
Megraud F (2003) Helicobacter pylori resistance to antibiotics: prevalence, mechanism, detection. What’s new? Can J Gastroenterol 17(Suppl B):49B–52B
Osato MS, Reddy SG, Piergies AA (2001) Comparative efficacy of new investigational agents against Helicobacter pylori. Aliment Pharmacol Ther 15:487–492
Perri F, Villani MR, Quitadamo M, Annese V, Niro GA, Andriulli A (2001) Ranitidine bismuth citrate-based triple therapies after failure of the standard ‘Maastricht triple therapy’: a promising alternative to the quadruple therapy? Aliment Pharmacol Ther 15:1017–1022
Rakshit S (2000) Prevalence of tetracycline resistance in Helicobacter. MS Thesis. Indiana State University
Ribeiro ML, Gerrits MM, Benvengo YH, Berning M, Godoy AP, Kuipers EJ, Mendonca S, van Vliet AH, Pedrazzoli JJ, Kusters JG (2004) Detection of high-level tetracycline resistance in clinical isolates of Helicobacter pylori using PCR-RFLP. FEMS Immunol Med Microbiol 40:57–61
Roberts MC (1996) Tetracycline resistance determinants: mechanism of action, regulation of expression, genetic mobility, and distribution. FEMS Microbiol Rev 19:1–24
Ross JI, Eady EA, Cove JH, Cunliffe WJ (1998) 16S rRNA mutation associated with tetracycline resistance in a gram-positive bacterium. Antimicrob Agents Chemother 42:1702–1705
Saenger W, Orth P, Kisker C, Hillen W, Hinrichs W (2000) The tetracycline repressor—a paradigm for a biological switch. Chem Int Ed 39:2042–2052
Saksena NK, Truffaut N (1993) Identification of the product of tetP gene: a possible mechanistic basis for tetracycline resistance in Clostridium perfringens. Folia Microbiol 38:15–21
Sambrook J, Fritsch EF, Maniatis T (1989) Molecular cloning: a laboratory manual, 2nd edn. Cold Spring Harbor Laboratory, Cold Spring Harbor, NY
Sicilia B, Sierra E, Lago A (2000) High eradication rates in Helicobacter pylori infection in patients with duodenal ulcer who failed previous eradication therapy. Med Clin (Barc) 115:641–643
Schwarz S, Cardoso M, Wegener HC (1992) Nucleotide sequence and phylogeny of the tet(L) tetracycline restitance determinant encoded by plasmid pSTE1 from Staphylococcus hyicus. Antimicrob Agents Chemother 36:580–588
Tomb JF, White O, Kerlavage AR, Clayton RA, Sutton GG, Fleischmann RD, Ketchum KA, Klenk HP, Gill S, Dougherty BA, Nelson K, Quackenbush J, Zhou L, Kirkness EF, Peterson S, Loftus B, Richardson D, Dodson R, Khalak HG, Glodek A, McKenney K, Fitzegerald LM, Lee N, Adams MD, Venter JC et al (1997) The complete genome sequence of the gastric pathogen Helicobacter pylori. Nature 388:539–647
Trieber CA, Taylor DE (2002) Mutations in the 16S rRNA genes of Helicobacter pylori mediate resistance to tetracycline. J Bacteriol 184:2131–2140
Wang Y, Roos KP, Taylor DE (1993) Transformation of Helicobacter pylori by chromosomal metronidazole resistance and by a plasmid with a selectable chloramphenicol resistance marker. J Gen Microbiol 139:2485–2493
Wang W, Guffanti AA, Wei Y, Ito M, Krulwich TA (2000) Two types of Bacillus subtilis tetA(L) deletion strains reveal the physiological importance of TetA(L) in K(+) acquisition as well as in Na(+), alkali, and tetracycline resistance. J Bacteriol 182:2088–2095
Woodall CA (2003) Electroporation of E. coli. Methods Mol Biol 235:55–69
Wu JY, Kim JJ, Reddy R, Wang WM, Graham DY, Kwon DH (2005) Tetracycline-resistant clinical Helicobacter pylori isolates with and without mutations in 16S rRNA-encoding genes. Antimicrob Agent Chemother 49:578–583
Acknowledgements
Thanks to the Department of Life Sciences, the Office of Sponsored Programs, and the School of Graduate Studies, Indiana State University for support of this project.
Author information
Authors and Affiliations
Corresponding author
Rights and permissions
About this article
Cite this article
Li, Y., Dannelly, H.K. Inactivation of the putative tetracycline resistance gene HP1165 in Helicobacter pylori led to loss of inducible tetracycline resistance. Arch Microbiol 185, 255–262 (2006). https://doi.org/10.1007/s00203-006-0093-9
Received:
Revised:
Accepted:
Published:
Issue Date:
DOI: https://doi.org/10.1007/s00203-006-0093-9